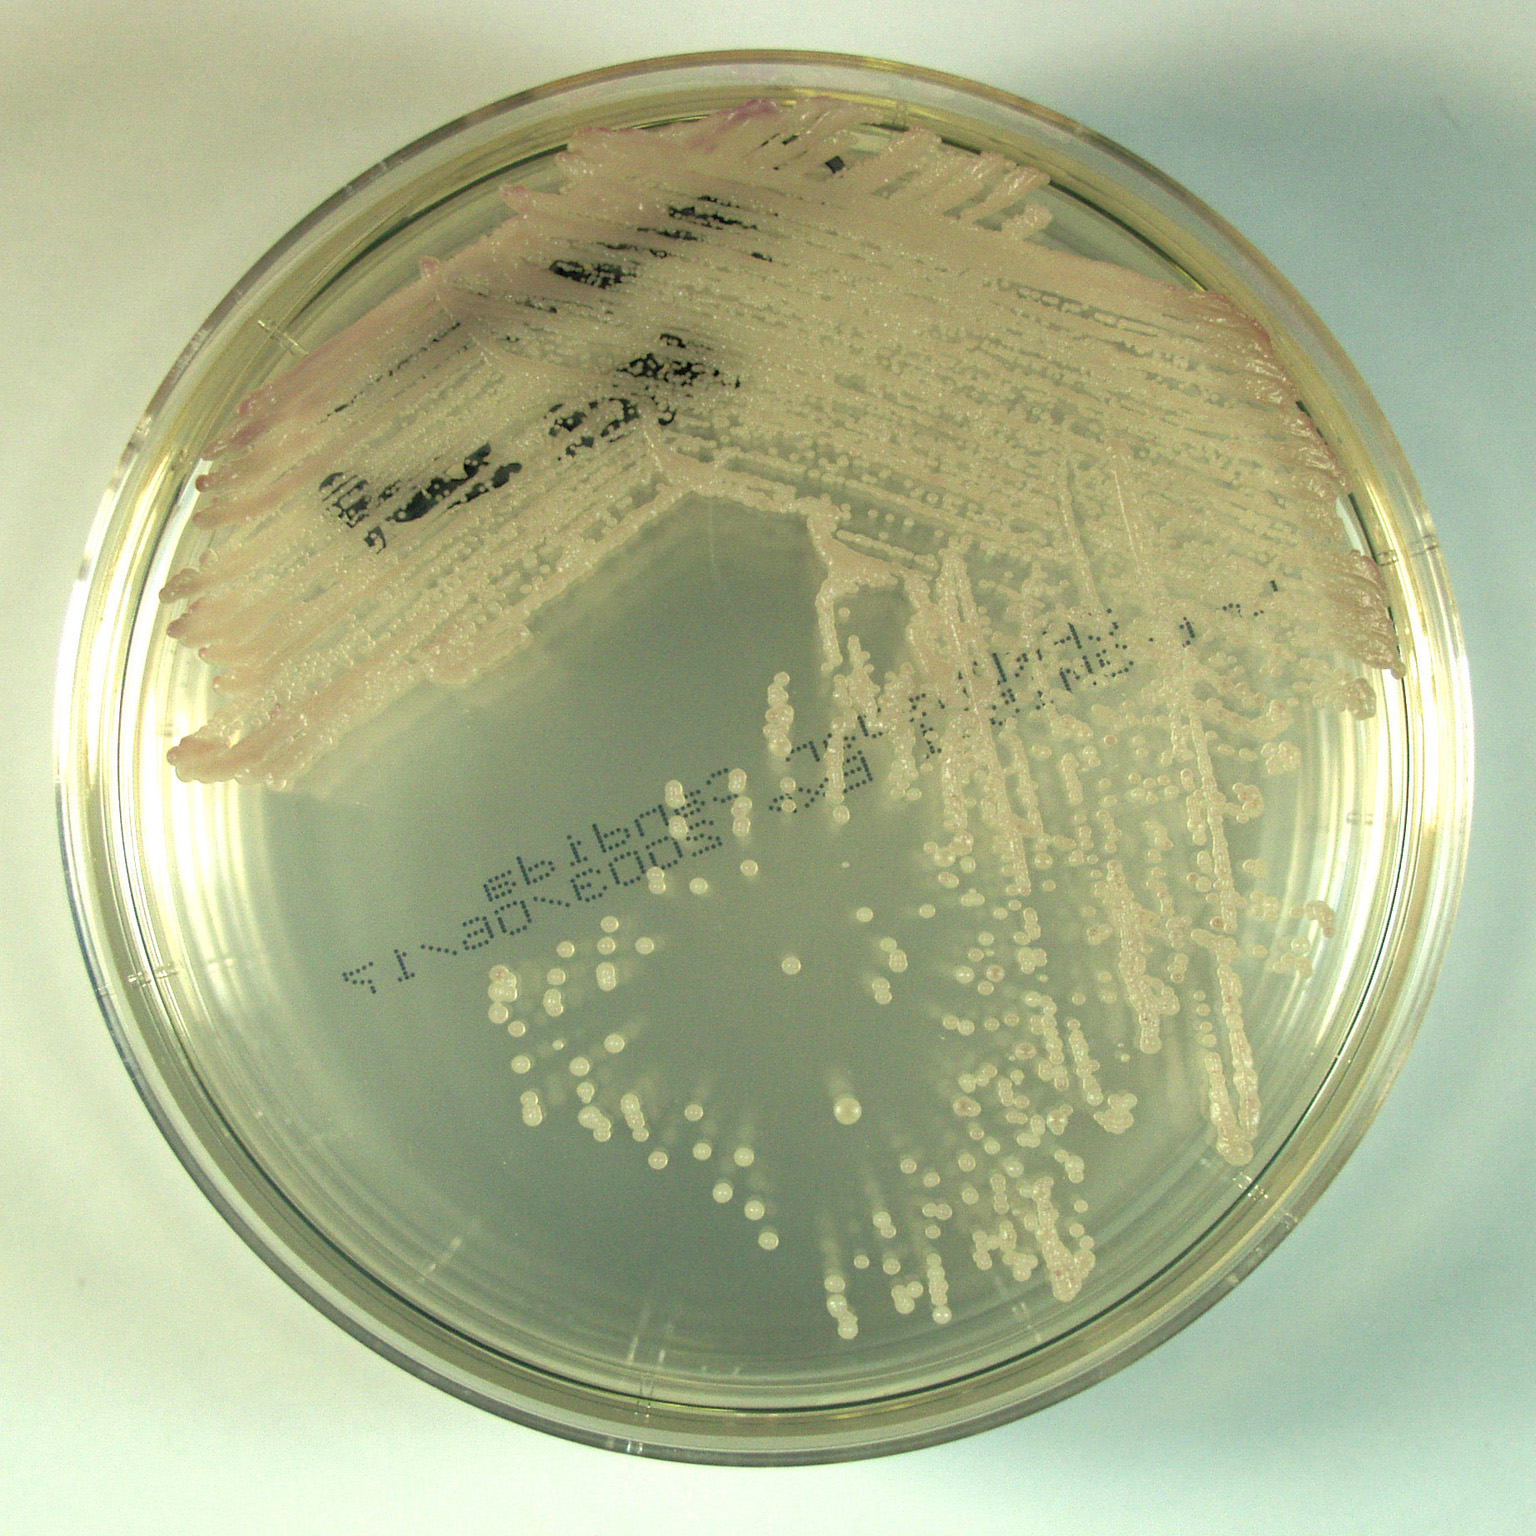

Кандида Парапсилозис

👉🏻👉🏻👉🏻 ВСЯ ИНФОРМАЦИЯ ДОСТУПНА ЗДЕСЬ, ЖМИТЕ 👈🏻👈🏻👈🏻
Купить Кофицил-плюс в Приморске
Купить Эротекс метро Бульвар Рокоссовского
Купить Урдокса в Оханске
Купить Кортимент метро Мякинино
Кандида Парапсилозис

_Candida_krusei.jpg" width="550" alt="Кандида Парапсилозис" title="Кандида Парапсилозис">









































